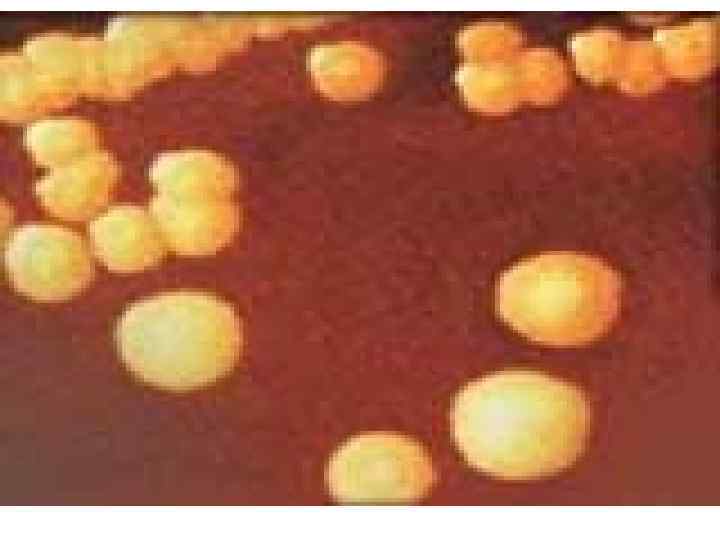
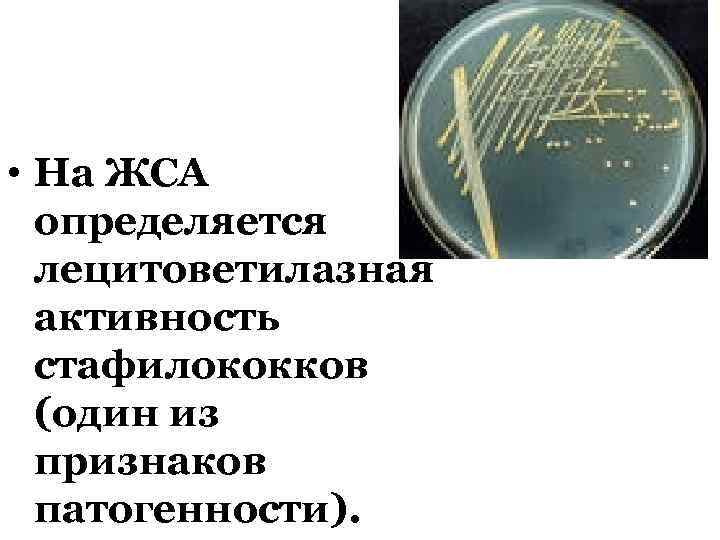
• На ЖСА определяется лецитоветилазная активность стафилококков (один из признаков патогенности).

Стафилококки - белая.ppt
- Количество слайдов: 66

КОККИ СТАФИЛОКОККИ Лектор: ассистент каф. микробиологии Черепанова Т. А.

Семейство Micrococcoceae Заболевание у человека вызывают представители 3 родов: ØStaphylococcus ØMicrococcus ØStomatococcus

Род Staphylococcus Стафилококки впервые обнаружены в 1880 году одновременно Л. Пастером и А. Огстоном. Подробное описание стафилококков было представлено в 1884 г. Ф. Розенбахом. Стафилококки принадлежат к наиболее популярным объектам медицинской микробиологии. Они являются одним из наиболее встречаемых микробов и являются спутником человека на протяжении всей его жизни во всех климатических зонах.

Описано 36 видов стафилококка. Из них 14 являются симбионтами (паразитами) человека. Различные виды связаны между собой умеренным генетическим родством. Гомология их ДНК (Г+Ц) 30 -39%. Человек и животные могут инфицироваться одними и теми же видами. Некоторые стафилококки выделяются преимущественно от животного или человека.

У человека доминируют три вида: ØS. aureus, ØS. epidermidis и ØS. saprophyticus. Почти все медицинские проблемы связаны со S. aureus, который до сих пор остается одним из эталонов бактериального госпитализма. За последние два десятилетия в госпитальной патологии возросла роль S. epidermidis и S. saprophyticus.

Стафилококковые заболевания в большинстве вторичны. Т. е. являются оппортунистическими инфекциями (англ. opportunity – удобный случай), протекая обычно по типу пиогенных осложнений. Вызывают ВБИ. Инвазивность современных диагностических и лечебных процедур способствуют внедрению бактерий. Стафилококки широко представлены в микрофлоре человека и окружающей среде.

В основе клинического разнообразия стафилококковой патологии лежит способность S. aureus вызывать: Øпиогенную инвазию кожи и ее придатков Øпроникать в кровь и вызывать пиогенные (гнойно-деструктивные) поражения внутренних органов Øвызывать неспецифическую (септическую) и Øспецифические интоксикации.

Стафилококковые болезни – группа различных заболеваний, обусловленная стафилококками. Основные проявления инфекции - гнойные заболевания кожи и подкожной клетчатки, пневмонии, стафилококковый сепсис, синдром токсического шока, энтероколит, гнойные ангины, отравление стафилококковым энтеротоксином и поражение центральной нервной системы.

Морфология Стафилококки – шаровидные бактерии 0, 5 – 1, 5 мкм в диаметре неподвижные, не образующие спор, образуют капсулу (S. aureus). Расположение микробов в мазке зависит от материала, из которого готовят препарат. Одно или двухсуточная агаровая культура в мазке образует типичные гроздьи винограда (греч. Staphylos – гроздь).



В мазках из гноя преобладают одиночные кокки. Мазки из бульонной культуры чаще всего выглядят в виде диплококков, монококков.

В гистологических срезах стафилококки расположены в виде больших скоплений (микроколоний). Под действием различных неблагоприятных факторов (антибиотики, некачественные среды) образуются большие шары или мелкие д- формы.

Окрашиваются по Граму положительно, старые культуры могут быть грамнеготивными.

Физиология По типу питания относятся к хемоорганотрофам, а по типу дыхания – факультат. анаэробы. Исключение составляют S. aureus subsp. anaerobius, S. saccharolyticus, чей рост в аэробных условиях невозможен или значительно подавлен из-за отсутствия у них каталазы. Стафилококки являются мезофиллами с температурным оптимумом для роста в интервале 30 -37º.

Неприхотливы к питательным субстратам. Довольно легко растут на обычных питательных средах. На плотных питательных средах они формируют пигментированные колонии цветом от белого до кремового, иногда желтого или оранжевого (пигменты являются липохромами нерастворимыми в воде и защищают от антиоксидантов). Пигмент особенно хорошо образуется в аэробных условиях, на свету. Для выявления пигментообразования предподчительно использовать ЖСА или МЖСА.

ЖСА и МЖСА – элективные и дифференциальнодиагностические среды. содержат Na. Cl в концентрациях от 4 до 20%. Способность к росту в гиперосмолярных условиях в присутствии высоких концентраций Na. Cl, что связано с наличием у них особых трансмембранных транспортных белков.

• На ЖСА определяется лецитоветилазная активность стафилококков (один из признаков патогенности).

На КМПА определяется гемолитическая активность.

КРОЛИЧЬЯ ПЛАЗМА ИСПОЛЬЗУЕТСЯ ДЛЯ ВЫЯВЛЕНИЯ ПЛАЗМОКОАГУЛАЗНОЙ АКТИВНОСТИ ПОЛОЖИТЕЛЬНЫЙ РЕЗУЛЬТАТ ОТРИЦАТЕЛЬНЫЙ РЕЗУЛЬТАТ

Антигенная структура Антигенные свойства проявляют вещества клеточной стенки: Øпептидогликан, Øбелок А, Øтейхоевые кислоты (полисахаридные антигены А, В, С), Øкапсула (для S. aureus). Пептидогликановые антигены общие для микрококков, стрептококков и стафилококков.

Белок А – антиген общий для S. aureus. Видоспецифичными являются полисахаридные антигены. ØПолисахарид А (рибитолтейхоевая кислота) характеризует S. aureus. ØПолисахарид В (глицеринтейхоевая кислота) – S. epidermidis. ØОба типа полисахаридов представлены у S. saprophyticus.

Патогенез стафилококковой инфекции В генезе стафилококкового заболевания играют роль два фактора – состояние иммунной системы макроорганизма и вирулентность возбудителя. Вирулентность стафилококков связана с необходимостью выживать в неблагоприятных условиях, обусловлена образований защитных структур, продукцией ферментов и токсинов, способностью к внутриклеточной персистенции.

Большое значение в патогенезе заболеваний имеет резистентность микробов к антибиотикам. В настоящее время более 90% золотистых стафилококков устойчивы к пенициллину, около 50% и более – к метициллину. Описаны внутрибольничные вспышки, связанные с эритромицинрезистентными штаммами золотистого стафилококка. По г. Чита более 73% золотистых стафилококков чувствительны к рифампицину, ципрофлоксацину.

В развитии стафилококковой инфекции участвуют структрные компоненты, фермент- и токсин зависимые механизмы. В каждом отдельном случае они могут быть выражены в разной степени. Факторами патогенности S. аureus следует считать капсулу, белок А, тейхоевые кислоты, пептидогликан, которые отнесены к микробзависимым (структурным) механизмам.

Повреждающее действие на клетки и ткани организма человека оказывают токсины и ферменты стафилококков. Аппарат агрессии (всего описано около 80 факторов агрессии) представляют: ферменты различной субстратной специфичности (протеазы, липазы, нуклеазы, плазмокоагулаза, фибринолизин и др. ), токсины и т. п.

Стафилококки продуцируют ряд токсинов. Энтеротоксины, ТSSТ (токсин септического шока), которые являются суперантигенами. Эти антигены способны связываться с β –цепью Т-клеточного рецептора, разнообразие которого (50 вариантов) позволяет активировать различные Т-клеточные клоны.

Т - лимфоциты в ответ на воздействие суперантигенов могут быть активированы в непредсказуемом варианте. Это либо гиперпродукция ИЛ 2, γ – интерферона, ФНО (по типу активации Тх1), либо активный синтез ИЛ-1, ИЛ-6, ИЛ-10 (по типу активации Тх2), а также могут инициировать апоптоз Т-клеток. В зависимости от того какой тип β–цепи Т-клеточного рецептора взаимодействовал с суперантигеном последствия могут различными: острая токсичность, шок, аутоиммунные болезни, иммунодефициты, онкогенез.

Этапы развития инфекции 1. Адгезия 2. Инвазия 3. Токсичность

Адгезия Обеспечивает прикрепление к различным биологическим и искусственным тканям. 1. Неспецифическая 2. Специфическая – взаимодействие за счет лигантов стафилококка и комплементарных им гликопротеидных или гликолипидных рецепторов на поверхности эукариотических клеток.

Прикрепление к эпителиоцитам осуществляется за счет: • тейхоевых кислот • специфического Са 2+- опосредованного взаимодействия структур стафилококка с карбогидратным компонентом муцина (к слизистой оболочки верхних дыхательных путей) • белковых адгезинов (клампингфактор для фибриногена).

S. aureus способен к адгезии на эндотелиоцитах, что приводит к поражению эндокарда, особенно органически измененных клапанов (после хирургических вмешательств, первичных атак ревматизма, изредка поражаются неповрежденные клапаны (чаще аортальные).

Прикрепление S. epidermidis к полимерным материалам за счет особого вида слизи «гликокаликса» или «слайма» , представляющего собой различные типы полисахаридов, связанные с полипептидами. Адгезия S. saprophyticus - за счет гемагглютининов, адгезинов для N-ацетилглюкозаминсвязывающих рецепторов II типа, фибронектина.

Инвазия Осуществляется за счет: гиалуронидазы (наделяет микроорганизм способностью к прохождению через соединительно-тканные барьеры), нейраминидазы (позволяет S. аureus проникать внутрь эпителиальных клеток и способствует длительному сохранению на слизистой оболочке верхних дыхательных путей, клетках протоков молочных желез, почечной ткани). Фибринолизин, (в качестве фибрин - специфического активатора плазминогена, способствует распространению в организме человека, растворяя фибриновые сгустки.

Токсичность Истинные экзотоксины не вызывают лизиса клеток, воздействуют на метаболизм через мембранные специфические рецепторы. 1. Эксфолиативные 2. Энтеротоксины Эксфолиатины: (ЭТА) термостабильный А (контролируется хромосомными генами), (ЭТВ) термолабильный В (контролируется плазмидными гена),

(ЭТС) вызывают нарушение межклеточных контактов зернистого слоя эпидермиса, что приводит к отслаиванию (эксфолиации) вышележащих слоев ороговевающего эпителия. Внешнее сходство с ожоговой поверхностью определило название – «синдром ошпаренной кожи» или «синдром ошпаренных младенцев» . . Около 50% штаммов золотистого стафилококка (чаще III фагогруппы) продуцируют токсины, которые, попав в пищеварительный тракт, вызывают острейший гастроэнтерит с тяжелой рвотой и профузным поносом. Рвота обусловлена прямым воздействием энтеротоксинов на центры головного мозга.

Энтеротоксины А, В, С, Д, Е а) вызывают ферментативный гидролиз никотинамиддиамина, ведет к АДФрибозилированию мембранных белков, что в свою очередь вызывает устойчивую активацию аденилатциклазной системы и накопление пула внутриклеточного ц. АМФ. Далее нарушение выхода из клеток мишеней воды, ионов хлора и поступление внутрь них ионов калия. б) Способны при попадании в кровеносное русло в дозе от 1 пкг/мл до 1 мкг/мл индуцировать Т-клеточную активацию и выработку цитокинов ( «суперантигенная» стимуляция).

СТШ (TSST)– токсин септического шока (гены токсинов связаны с умеренными фагами, но экспрессируются редко), вызывает заболевание, характеризующееся внезапным подъемом температуры, рвотой, профузным поносом, мышечными болями, быстро прогрессирующей гипотонией, вплоть до шока. Типичный признак – скарлатинозная сыпь, которая шелушится неделю и более, особенно на ладонях и стопах.

Цитолизины- факторы с мембраноповреждающим эффектом, разрушающие клеточные структуры макроорганизма: «гемолизины» (в частности известно 4 гемолизина эритроцитов (альфа-, бета-, гамма- и дельта-токсины). ØАльфа-токсин при подкожном введении животным вызывает некроз кожи. ØДельта-токсин ингибирует всасывание воды в подвздошной кишке, вызывает водянистую диарею).

Развитию заболевания способствует межмикробный антогонизм, который осуществляется за счет: 1. Бактериолизинов 2. Бактериоцинов 3. Ферамонов

Бактериолизины: 1. Бактериолизины: лизостафин одних видов стафилококков разрушает клеточные стенки других видов, пептидогликановые гидролазы, лизоцим, ацетилглюкозаминидаза. 2. Бактериоцины: Лантибиотики и β-лизин повреждают ЦПМ клеток мешеней 3. Феромоны: октапептид RAP.

Особенности иммунитета при стафилококковой инфекции üПервая связана с наличием иммуномодулирующих или иммунотоксических эффектов субстанций стафилококков. üВторая – со свойствами, имеющих самостоятельное значение в обеспечении состояния иммунорезистентности стафилококков.

Подобные факторы можно разделить на «пассивные» , с помощью которых стафилококки уклоняются от контакта с иммунной системой, и «активные» , направленные на сохранение жизнеспособности стафилококков при непосредственном взаимодействии с гуморальными и клеточными механизмами противоинфекционной резистентности, что рассматривается как более агрессивный вариант.

«Пассивные механизмы» üЭкранирование клеточной стенки стафилококков поверхностно расположенными структурами, образуемыми in vivo из молекул хозяина; üОбразование молекул, структурно и функционально схожих с протеинами хозяина и, таким образом, сообщающих патогену состояние «антигенной мимикрии» ; üПереход в состояние «покоящихся форм» со сниженной метаболической активностью и репродуктивным потенциалом; üУтрата наиболее чужеродных в антигенном отношении фрагментов клеточной стенки с образованием L-форм.

Капсулообразование рассматривается в качестве одного из наиболее универсальных механизмов иммунорезистентности стафилококков. Экранировку клеточной стенки в первую очередь обеспечивают уроновые кислоты полисахаридных капсул. Капсулоподобное образование продуцирует S. epidermidis и некоторые другие виды КОС. Капсулообразующие стафилококки защищены от опсонизации иммуноглобулинами и компонентами системы комплемента.

Это приводит к нарушению поглощения фагоцитами. Слабая опсонизация объясняется также слабым ИО при стафилококковой инфекции, который не обеспечивает необходимого количества опсонически активных антител, в частности антипептидогликановых антител. У больных хроническим остеомиелитом обнаружены антитела, блокирующие опсоническую активность противостафилококковых антител здоровых людей.

Сходный механизм нарушения фагоцитарной активности связан образованием in vivo «псевдокапсулы» некоторыми штаммами стафилококков из белковых структур организма хозяина. В образовании «псевдокапсулы» принимают участие внеклеточная плазмокоагулаза, а также рецептор для фибриногена (клампинг-фактор), локализованный в клеточной стенке S. aureus. Оба фактора участвуют в формировании протеинового покрова вокруг клеток и микроколоний стафилококков.

Уклонение стафилококков от факторов иммунитета связано с «антигенной мимикрией» - наличием общих антигенных детерминант стафилококка с молекулами и клетками организма хозяина.

Высокая частота бактерионосительства и стафилококковых заболеваний, склонных к затяжному и рецидивирующему течению, отмечена в человеческих популяциях, имеющих А (II) группу крови. Это связано с идентичностью группоспецифического фактора А эритроцитов человека и корпускулярного стафилококкового антигена. Сходство этих антигенов объясняет более легкое достижение ремиссии стафилококкового процесса у больных с группой крови В(III), в сыворотке которых имеются ά-изогемагглютинины.

Снижение интенсивности антигенного раздражения при стафилококковой инфекции может достигаться за счет значительного снижения метаболической и репродуктивной активности при переходе в состояние, близкое к «покоящимся формам» . Радикальный механизм защиты стафилококков - в способности образования L-форм бактерий, которые являются слабым антигенным раздражителем для распознающих механизмов иммунной системы.

Дополнительной характеристикой таких вариантов S. аureus, обеспечивающих возможность избегать контакт с эффекторами иммунитета, является способность к длительному переживанию внутри непрофессиональных фагоцитов. В этом случае микроорганизмы как бы «выводятся из поля зрения» иммунной системы, так как отделены от факторов иммунитета цитоплазматической мембраной эукариотической клетки.

« Активные механизмы» üПродукция секретируемых факторов, инактивирующих гуморальные защитные механизмы организма хозяина и нарушающих процессы опсонической кооперации; üВозникновение факторов, нарушающих процесс внутриклеточного киллинга стафилококков профессиональными и непрофессиональными фагоцитами; Появление факторов, вызывающих повреждение и гибель иммунокомпетентных клеток.

Механизмы иммунорезистентности стафилококков связаны с их устойчивостью как к гуморальным, так и клеточным защитным системам организма человека. Наиболее изученным свойством стафилококков, направленным на инактивацию гуморальных факторов иммунологической защиты, считается их способность к образованию на поверхности клеточной стенки протеина А.

Белок А на своей поверхности содержит 4 сайта, которые способны соединяться с Fcфрагментом иммуноглобулинов, вызывая при этом их блокировку. При наличии белка А молекулы Ig G, субкласса Ig A 2 фиксируются на микробной клеточной стенке в «перевернутом» виде через свой Fc -фрагмент. Этим феном объясняется нарушение процесса опсонизации фагоцитов.

Большую роль в супрессии иммунного ответа играет не связанный с клетками белок А, который секретируется стафилококками в окружающую среду Свободный белок А (составляет до 1/10 общего количества синтезируемого протеина А) способен приводить к истощению комплемента, так как способен запускать КПК и АПК без его фиксации на поверхности бактериальной клетки и нарушать процесс опсонофагоцитоза.

Протеин А в комплексе с комплементом оказывают тромбоцитоповреждающее действие, способны самостоятельно индуцировать ГЗТ, а также способны взаимодействовать с рецепторами В-лимфоцитов по аналогии с взаимодействием с рецепторами Т-лимфоцитов стафилококковых суперантигенов.

Протеазы стафилококков осуществляют ферментативную деградацию иммуноглобулинов классов G, A и M и факторов противоинфекционной резистентности, таких как C 1 q- компонент комплемента и γинтерферон.

Устойчивость стафилококков к клеточным бактерицидным системам организма связана с üослаблением хемотаксиса фагоцитов, üпрепятствием контакту патогена с лизосомальным аппаратом фагоцитов, üспособностью бактериальных продуктов к инактивации антимикробных субстанций лизосом.

Захват стафилококков фагоцитами не сопровождается его эффективным киллингом и может привести к гибели самой эукариотической клетки. После проникновения в фагоцит стафилококки избегают контакта с лизосомами и, вызывая лизис мембраны эндосомы, попадают в цитоплазму. В фагоците S. аureus размножается и на определенном этапе запускает апоптоз клетки хозяина.

Антилизосомальная активность стафилококков связана с продукцией каталазы и супероксиддисмутазы. За резистентность к кислороднезависимым бактерицидным субстанциям лейкоцитов ответсвенны антилизоцимный фактор в совокупности с антиинтерфероновым.

К «активным» факторам иммунорезистентности стафилококков отнесены свойства микроба, направленные на обеспечение выживания патогена во внутренней среде организма хозяина через нарушение жизнеспособности иммунокомпетентных клеток. Стафилококки секретируют ряд мембранотоксинов, которые образуют микроканалы в эритроцитах, лейкоцитах и других клетках. Это приводит к нарушению осмотического давления и лизису соответствующих клеток.

Так α-гемолизин разрушает эритроциты, лейкоциты и клетки соединительной ткани, β-гемолизин угнетает хемотаксис полиморфноядерных лейкоцитов, γ-гемолизин повреждает эритроциты, лейкоциты. Лейкоцидин разрушает только клетки белой крови, вызывая дегрануляцию полиморфно-ядерных лейкоцитов и макрофагов. Таким образом, мембранотоксины оказывают повреждающий эффект на фагоциты, Т-лимфоциты и т. п.

Таким образом, мембранотоксины оказывают повреждающий эффект на фагоциты, Т-лимфоциты и т. п. Суперантигены вызывают иммуносупрессивный эффект.

Иммунитет к S. аureus никогда не бывает полным и поэтому стафилококк сохраняет потенциальную болезнетворность, реализуя ее в подходящих условиях.

Стафилококки - белая.ppt